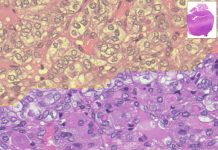
Analisi più rapida ed efficace dei tumori con il supporto dell’IA

Per disfagia si intende una condizione clinica complessa – che può essere provocata da anomalie funzionali o strutturali di cavità orale, faringe, esofago o cardias – e che si manifesta con difficoltà di progressione del bolo alimentare dalla bocca allo stomaco.
Esordio, evoluzione clinica e gravità della malattia dipendono dalla causa alla base del problema e dalla presenza di eventuali comorbibità.
La patologia si manifesta principalmente in età infantile, in bambini che hanno subito paralisi cerebrale o presentano difficoltà inabilitanti dello sviluppo, e in età avanzata, come conseguenza dell’invecchiamento (in questo caso si parla di presbifagia).
Incidenza della disfagia
Si stima che la disfagia colpisca circa il 13% della popolazione generale dopo i 65 anni di età e che una persona su 17 possa soffrire di disfagia nel corso della vita.
La percentuale di pazienti disfagici supera il 50% della popolazione anziana ospedalizzata o in RSA e si manifesta nel 40-70% delle persone che hanno subito un ictus-
Nei casi più gravi, il paziente disfagico non riesce ad assumere cibo in quantità e qualità adeguata, con rischi di malnutrizione, disidratazione e passaggio di cibo nelle vie respiratorie, con conseguenze spesso gravi, come, per esempio, lo sviluppo di polmoniti.
Disfagia, classificazione e cause
La classificazione della disfagia può essere effettuata dal punto di vista sia anatomico sia funzionale:
| CLASSIFICAZIONE ANATOMICA | CLASSIFICAZIONE FISIOPATOLOGICA |
| Disfagia oro-faringea | Disfagia neuro-muscolare (funzionale) |
| Disfagia esofagea | Disfagia strutturale (meccanica) |
Nella disfagia pre-esofagea la difficoltà di transito risiede nel passaggio del materiale dall’oro-faringe all’esofago cervicale. In questo caso sono interessate strutture poste in prossimità dell’esofago e la causa va spesso ricercata in malattie neurologiche o muscolari, quali la dermatopolimiosite, la miastenia grave, le paralisi pseudobulbari.
La disfagia esofagea può avere cause ostruttive o motorie.
Nel primo caso, la disfagia è solitamente per i solidi e può essere causata da:
- carcinoma esofageo;
- stenosi peptidiche benigne;
- stenosi cicatriziali;
- restrizioni anulari (se nell’esofago inferiore: anello di Schatzki, che abitualmente dà disfagia solida intermittente).
Tra le cause motorie si annoverano:
- acalasia;
- spasmo esofageo diffuso sintomatico;
- sclerodermia.
Le cause motorie di disfagia interessano la muscolatura liscia dell’esofago e danno abitualmente disfagia per i liquidi, specie se troppo caldi o troppo freddi, o disfagia mista.
Approccio diagnostico
Il sospetto di disfagia viene formulato dal medico curante in base al rilievo di alcuni “campanelli d’allarme” e/o di particolari sintomi rilevati durante l’esame obiettivo. Nei casi dubbi è consigliabile effettuare anche lo screening delle capacità deglutitorie.
L’iter diagnostico è riassunto nella flow-chart: Algoritmo diagnostico della disfagia.
Individuazione di sospetta disfagia
L’individuazione del paziente sospetto disfagico si effettua da parte del medico curante dal rilievo, eventualmente su segnalazione del paziente stesso o dei suoi care-giver, di alcuni “campanelli d’allarme”:
• fastidio o dolore associato alla deglutizione
• allungamento del tempo dedicato al pasto
• tosse costante durante i pasti
• senso di corpo estraneo in gola
• alterazione della voce durante e/o dopo la deglutizione
• progressivo cambiamento delle abitudini alimentari nelle consistenze dei cibi e nella quantità
• calo ponderale senza causa apparente
• rialzo termico ricorrente senza cause note.
Esame obiettivo
Il medico, inoltre, potrà sospettare la presenza di disturbi deglutitori obiettivando alcuni dei seguenti sintomi:
• alterato livello di coscienza
• linguaggio mal articolato
• gestione difficoltosa delle secrezioni orali e/o scialorrea
• qualsiasi segno indicatore di ridotta funzione laringea (riduzione della voce o/e della tosse volontaria)
• rischio documentato di disfagia o aspirazione durante ricoveri precedenti
• dispnea (f.r.>30 atti/minuto, desaturazione)
Presenza di complicanze della disfagia:
• malnutrizione per cause non altrimenti identificabili;
• disidratazione per cause non altrimenti identificabili;
• polmonite da aspirazione o inalazione.
Screening delle capacità deglutitorie
Nei casi dubbi è consigliabile effettuare lo screening delle capacità deglutitorie
Lo screening delle capacità deglutitori può essere effettuato dal medico curante o da personale infermieristico debitamente formato.
Terapia nutrizionale per il paziente disfagico
La terapia nutrizionale deve prendere in considerazione sia la via di somministrazione, orale o enterale, sia la via di accesso, qualora la nutrizione per bocca non sia indicata
Per decidere quale approccio nutrizionale adottare con un paziente disfagico, è necessario considerare molteplici parametri:
- Evoluzione naturale della malattia
- Prognosi della malattia
- Capacità cognitive del paziente
- Tipo e grado di disfagia
- Possibilità e tempi di recupero
- Stato nutrizionale
Sulla base di tutti questi parametri viene impostata la terapia nutrizionale che prende in considerazione sia la via di somministrazione, orale o enterale, sia la via di accesso, qualora la nutrizione per bocca non sia indicata.
Ove possibile, la via orale deve essere la prima scelta, ma solo se la deglutizione risulta sicura ed efficace.
Se il paziente riesce a coprire almeno il 60% dei fabbisogni calorico-proteici stimati, attraverso la deglutizione orale, può essere presa in considerazione una supplementazione con integratori.
In caso invece di apporti inferiori al 60%, si dovrebbe considerare l’opportunità di una nutrizione enterale tramite sonda.
| PIANO ALIMENTARE NELLA DISFAGIA | |
| Obiettivo | Specifiche |
| Deglutizione sicura | Modificare la consistenza di cibi e bevande per ridurre il rischio di soffocamento e di aspirazione. |
| Apporto nutrizionale | Deve essere adeguato per prevenire o correggere la malnutrizione e/o la disidratazione. |
| Gusti del paziente | Proporre cibi invitanti nel rispetto dei gusti del paziente. |
| Autonomia | Favorire l’autonomia durante il pasto |
Come approfondire
I professionisti sanitari interessati o, a diverso titolo, coinvolti in screening diagnostico, trattamento nutrizionale, gestione dei pazienti fragili e con possibile disfagia e alterato stato nutrizionale, possono avvalersi del supporto offerto dalla piattaforma